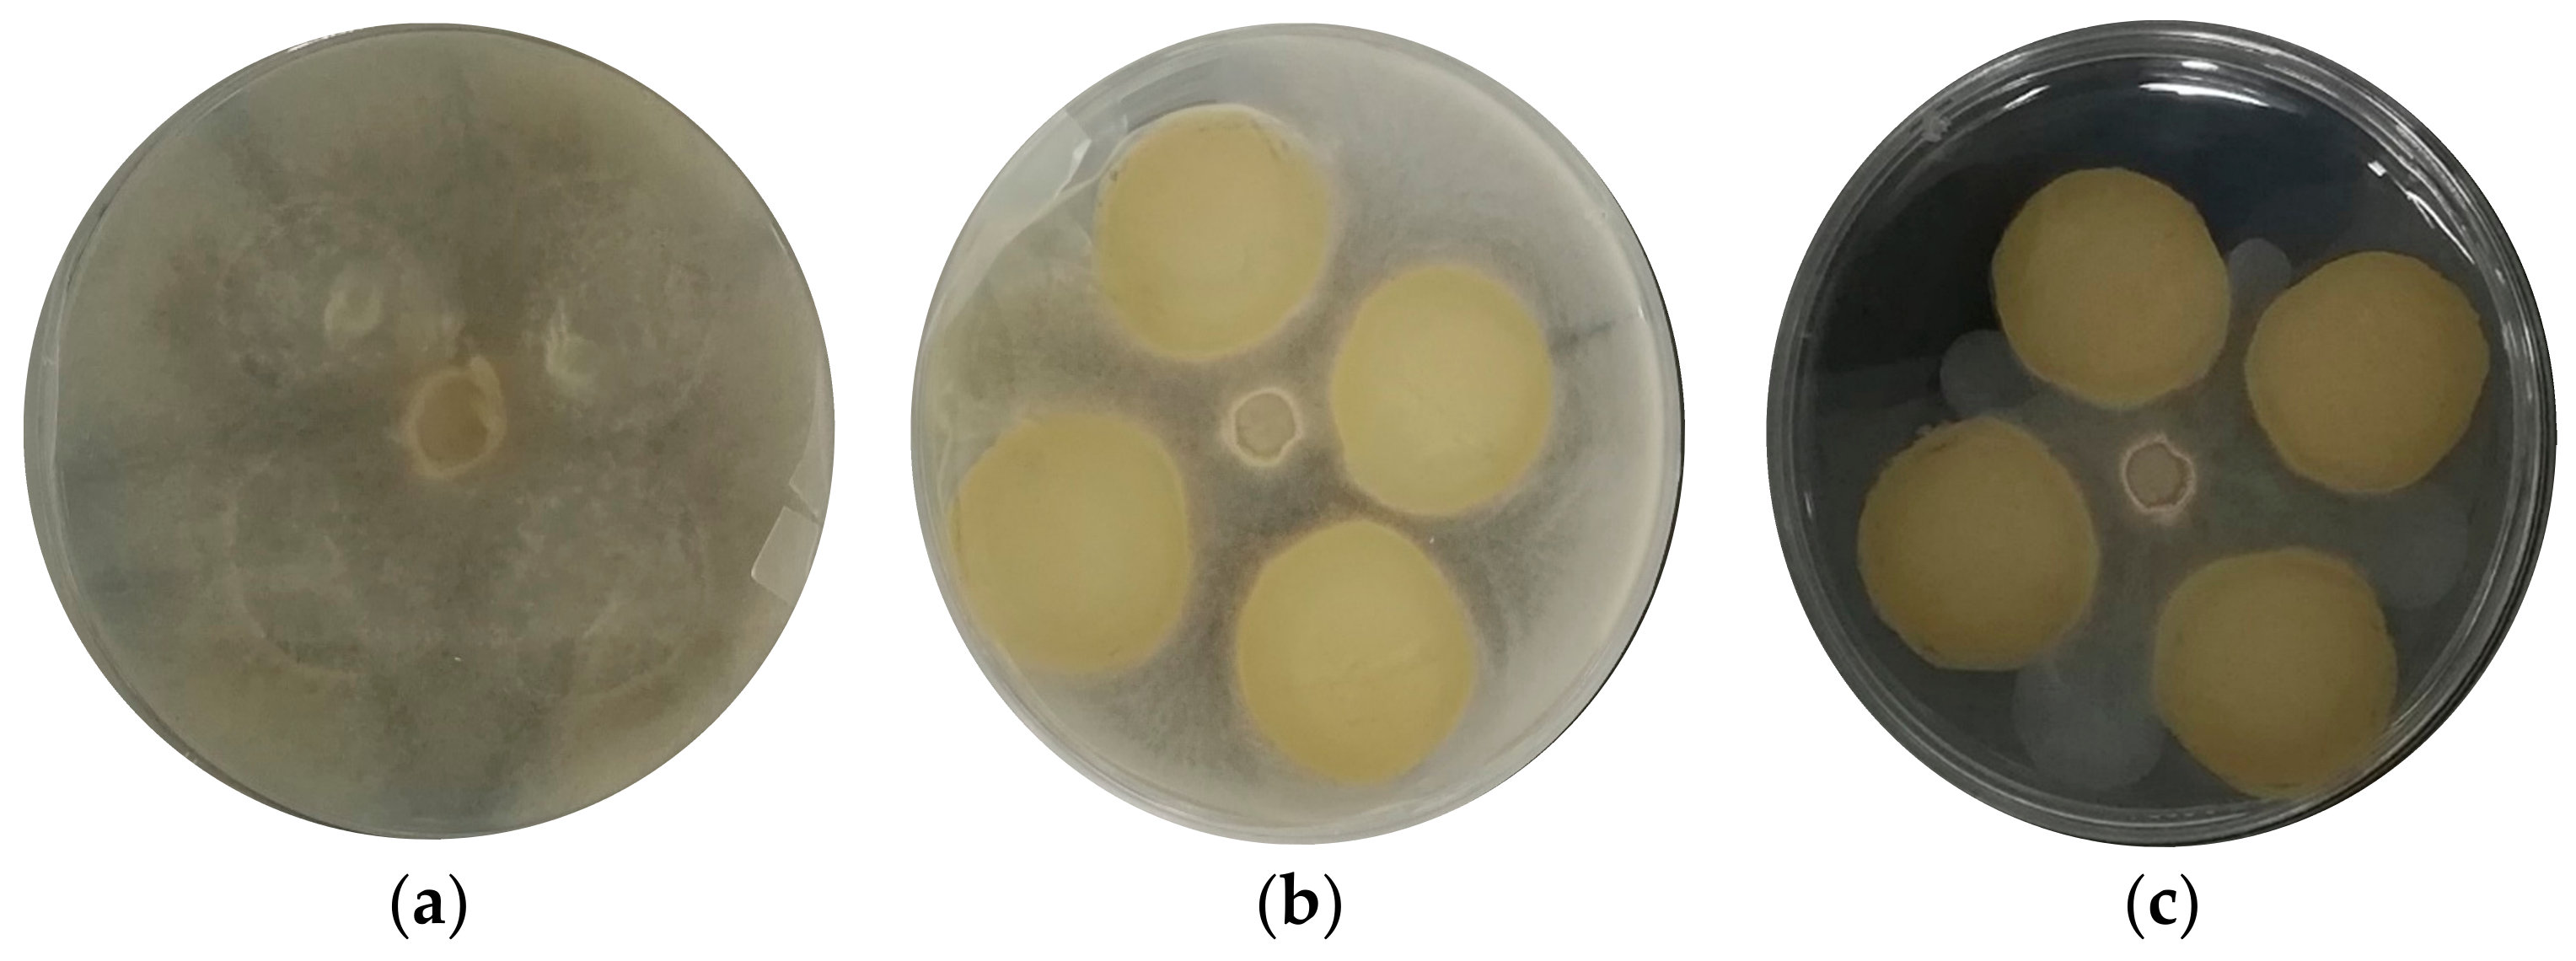
Foods 12 01633 g005 Foods 12 01633 g005

Development and Characterization of Films with Propolis to Inhibit Mold Contamination in the Dairy Industry
Abstract
1. Introduction
2. Materials and Methods
2.1. Antifungal Agent Extraction
2.2. Determination of Total Polyphenols
2.3. Minimum Inhibitory Concentration (MIC)
2.4. Preparation of the Antifungal Film
2.5. Film Characterization
2.5.1. Thermogravimetric Analysis (TGA)
2.5.2. Color
2.5.3. Opacity Index
2.5.4. Film Thickness
2.5.5. Film Morphology
2.5.6. Fourier Transform Infrared Spectroscopy (FTIR)
2.6. Antifungal Activity
2.6.1. In Vitro Evaluation of the Antifungal Activity of the Film against Filamentous Molds
2.6.2. Evaluation of the Antifungal Activity of the Film/Coating against Filamentous Molds in Pieces of Cheese
2.7. Statistical Analysis
3. Results and Discussion
3.1. Concentration of Total Phenolic Compounds in the Ethanolic Extract of Propolis
3.2. Minimum Inhibitory Concentration (MIC)
3.3. Thermogravimetric Analysis (TGA)
3.4. Color and Opacity
3.5. Thickness
3.6. Morphology
3.7. Fourier Transform Infrared Spectroscopy (FTIR)
3.8. Evaluation of the Antifungal Activity of the Films against Filamentous Fungi and Ripened Cheese
4. Conclusions
Author Contributions
Funding
Data Availability Statement
Acknowledgments
Conflicts of Interest
References
- Buehler, A.J.; Evanowski, R.L.; Martin, N.H.; Boor, K.J.; Wiedmann, M. Internal Transcribed Spacer (ITS) Sequencing Reveals Considerable Fungal Diversity in Dairy Products. J. Dairy Sci. 2017, 100, 8814–8825. [Google Scholar] [CrossRef] [PubMed]
- Bernardi, A.O.; Stefanello, A.; Garcia, M.V.; Copetti, M.V. The Control of Cheese and Meat Product Spoilage Fungi by Sanitizers: In Vitro Testing and Food Industry Usage. LWT 2021, 144, 111204. [Google Scholar] [CrossRef]
- McSweeney, P.; Cotter, P.; Everett, D. Cheese; Academic Press: Cambridge, MA, USA, 2017. [Google Scholar]
- Fox, P.F.; Guinee, T.P.; Cogan, T.M.; Mcsweeney, P.L.H. Fundamentals of Cheese Science; Springer: New York, NY, USA, 2017. [Google Scholar]
- Garnier, L.; Valence, F.; Mounier, J. Diversity and Control of Spoilage Fungi in Dairy Products: An Update. Microorganisms 2017, 5, 42. [Google Scholar] [CrossRef] [PubMed]
- Martin, N.H.; Snyder, A.; Wiedmann, M. Spoilage Mold in Dairy Products. In Encyclopedia of Dairy Sciences; Elsevier: Amsterdam, The Netherlands, 2022; pp. 607–610. [Google Scholar]
- Snyder, A.B.; Worobo, R.W. Fungal Spoilage in Food Processing. J. Food Prot. 2018, 81, 1035–1040. [Google Scholar] [CrossRef] [PubMed]
- Banjara, N.; Suhr, M.J.; Hallen-Adams, H.E. Diversity of Yeast and Mold Species from a Variety of Cheese Types. Curr. Microbiol. 2015, 70, 792–800. [Google Scholar] [CrossRef]
- Kandasamy, S.; Park, W.S.; Yoo, J.; Yun, J.; Kang, H.B.; Seol, K.-H.; Oh, M.-H.; Ham, J.S. Characterisation of Fungal Contamination Sources for Use in Quality Management of Cheese Production Farms in Korea. Asian-Australas. J. Anim. Sci. 2020, 33, 1002–1011. [Google Scholar] [CrossRef]
- Possas, A.; Bonilla-Luque, O.M.; Valero, A. From Cheese-Making to Consumption: Exploring the Microbial Safety of Cheeses through Predictive Microbiology Models. Foods 2021, 10, 355. [Google Scholar] [CrossRef]
- Berti, S.; Ollé Resa, C.P.; Basanta, F.; Gerschenson, L.N.; Jagus, R.J. Edible Coatings on Gouda Cheese as a Barrier against External Contamination during Ripening. Food Biosci. 2019, 31, 100447. [Google Scholar] [CrossRef]
- Kim, J.H.; Tam, C.C.; Chan, K.L.; Cheng, L.W.; Land, K.M.; Friedman, M.; Chang, P.-K. Antifungal Efficacy of Redox-Active Natamycin against Some Foodborne Fungi-Comparison with Aspergillus Fumigatus. Foods 2021, 10, 2073. [Google Scholar] [CrossRef]
- Costa, M.J.; Maciel, L.C.; Teixeira, J.A.; Vicente, A.A.; Cerqueira, M.A. Use of Edible Films and Coatings in Cheese Preservation: Opportunities and Challenges. Food Res. Int. 2018, 107, 84–92. [Google Scholar] [CrossRef]
- Correa-Pacheco, Z.N.; Bautista-Baños, S.; Ramos-García, M.D.L.; Martínez-González, M.D.C.; Hernández-Romano, J. Physicochemical Characterization and Antimicrobial Activity of Edible Propolis-Chitosan Nanoparticle Films. Prog. Org. Coat. 2019, 137, 105326. [Google Scholar] [CrossRef]
- Mahcene, Z.; Khelil, A.; Hasni, S.; Akman, P.K.; Bozkurt, F.; Birech, K.; Goudjil, M.B.; Tornuk, F. Development and Characterization of Sodium Alginate Based Active Edible Films Incorporated with Essential Oils of Some Medicinal Plants. Int. J. Biol. Macromol. 2020, 145, 124–132. [Google Scholar] [CrossRef]
- Bonilla, J.; Sobral, P.J.A. Investigation of the Physicochemical, Antimicrobial and Antioxidant Properties of Gelatin-Chitosan Edible Film Mixed with Plant Ethanolic Extracts. Food Biosci. 2016, 16, 17–25. [Google Scholar] [CrossRef]
- Bagheri, F.; Radi, M.; Amiri, S. Drying Conditions Highly Influence the Characteristics of Glycerol-Plasticized Alginate Films. Food Hydrocoll. 2019, 90, 162–171. [Google Scholar] [CrossRef]
- Huang, D.; Zhang, Z.; Ma, Z.; Quan, Q. Effect of Natural Nanostructured Rods and Platelets on Mechanical and Water Resistance Properties of Alginate-Based Nanocomposites. Front. Chem. 2018, 6, 635. [Google Scholar] [CrossRef]
- Ramón-Sierra, J.; Peraza-López, E.; Rodríguez-Borges, R.; Yam-Puc, A.; Madera-Santana, T.; Ortiz-Vázquez, E. Partial Characterization of Ethanolic Extract of Melipona Beecheii Propolis and in Vitro Evaluation of Its Antifungal Activity. Rev. Bras. Farmacogn. 2019, 29, 319–324. [Google Scholar] [CrossRef]
- Siripatrawan, U.; Vitchayakitti, W. Improving Functional Properties of Chitosan Films as Active Food Packaging by Incorporating with Propolis. Food Hydrocoll. 2016, 61, 695–702. [Google Scholar] [CrossRef]
- Anjum, S.I.; Ullah, A.; Khan, K.A.; Attaullah, M.; Khan, H.; Ali, H.; Bashir, M.A.; Tahir, M.; Ansari, M.J.; Ghramh, H.A.; et al. Composition and Functional Properties of Propolis (Bee Glue): A Review. Saudi J. Biol. Sci. 2019, 26, 1695–1703. [Google Scholar] [CrossRef]
- Huang, S.; Zhang, C.-P.; Wang, K.; Li, G.; Hu, F.-L. Recent Advances in the Chemical Composition of Propolis. Molecules 2014, 19, 19610–19632. [Google Scholar] [CrossRef]
- Mattiuz, B.-H.; Ducamp-Collin, M.-N.; Mattiuz, C.F.M.; Vigneault, C.; Marques, K.M.; Sagoua, W.; Montet, D. Effect of Propolis on Postharvest Control of Anthracnose and Quality Parameters of ‘Kent’ Mango. Sci. Hortic. 2015, 184, 160–168. [Google Scholar] [CrossRef]
- Santos-Buelga, C.; González-Paramás, A.M. Chemical composition of honey. In Bee Products-Chemical and Biological Properties; Springer: Berlin/Heidelberg, Germany, 2017. [Google Scholar]
- Jonaidi Jafari, N.; Kargozari, M.; Ranjbar, R.; Rostami, H.; Hamedi, H. The Effect of Chitosan Coating Incorporated with Ethanolic Extract of Propolis on the Quality of Refrigerated Chicken Fillet. J. Food Process. Preserv. 2018, 42, e13336. [Google Scholar] [CrossRef]
- De Lima, G.G.; de Souza, R.O.; Bozzi, A.D.; Poplawska, M.A.; Devine, D.M.; Nugent, M.J.D. Extraction Method Plays Critical Role in Antibacterial Activity of Propolis-Loaded Hydrogels. J. Pharm. Sci. 2016, 105, 1248–1257. [Google Scholar] [CrossRef] [PubMed]
- Reyes, L.M.; Landgraf, M.; Sobral, P.J.A. Gelatin-Based Films Activated with Red Propolis Ethanolic Extract and Essential Oils. Food Packag. Shelf Life 2021, 27, 100607. [Google Scholar] [CrossRef]
- Abarca, R.L.; Rodríguez, F.J.; Guarda, A.; Galotto, M.J.; Bruna, J.E.; Fávaro Perez, M.A.; Ramos Souza Felipe, F.; Padula, M. Application of β-Cyclodextrin/2-Nonanone Inclusion Complex as Active Agent to Design of Antimicrobial Packaging Films for Control of Botrytis Cinerea. Food Bioprocess Technol. 2017, 10, 1585–1594. [Google Scholar] [CrossRef]
- Abarca, R.L.; Medina, J.; Alvarado, N.; Ortiz, P.A.; López, B.C. Biodegradable Gelatin-Based Films with Nisin and EDTA That Inhibit Escherichia Coli. PLoS ONE 2022, 17, e264851. [Google Scholar] [CrossRef]
- Abarca, R.L.; Rodríguez, F.J.; Guarda, A.; Galotto, M.J.; Bruna, J.E. Characterization of Beta-Cyclodextrin Inclusion Complexes Containing an Essential Oil Component. Food Chem. 2016, 196, 968–975. [Google Scholar] [CrossRef]
- Cheng, M.; Wang, J.; Zhang, R.; Kong, R.; Lu, W.; Wang, X. Characterization and Application of the Microencapsulated Carvacrol/Sodium Alginate Films as Food Packaging Materials. Int. J. Biol. Macromol. 2019, 141, 259–267. [Google Scholar] [CrossRef]
- Salama, H.E.; Abdel Aziz, M.S.; Sabaa, M.W. Novel Biodegradable and Antibacterial Edible Films Based on Alginate and Chitosan Biguanidine Hydrochloride. Int. J. Biol. Macromol. 2018, 116, 443–450. [Google Scholar] [CrossRef]
- Solano, R.J.; Sierra, C.A.; Ávila Murillo, M. Antifungal Activity of LDPE/Lauric Acid Films against Colletotrichum Tamarilloi. Food Packag. Shelf Life 2020, 24, 100495. [Google Scholar] [CrossRef]
- Tabassum, N.; Khan, M.A. Modified Atmosphere Packaging of Fresh-Cut Papaya Using Alginate Based Edible Coating: Quality Evaluation and Shelf Life Study. Sci. Hortic. 2020, 259, 108853. [Google Scholar] [CrossRef]
- Zhang, J.; Shen, X.; Wang, K.; Cao, X.; Zhang, C.; Zheng, H.; Hu, F. Antioxidant Activities and Molecular Mechanisms of the Ethanol Extracts of Baccharis Propolis and Eucalyptus Propolis in RAW64.7 Cells. Pharm. Biol. 2016, 54, 2220–2235. [Google Scholar] [CrossRef]
- Moncayo Luján, M.D.R.; Moreno Reséndez, A.; Galván Barrón, G.S.; Reyes Carrillo, J.L.; Carrillo Inungaray, M.L. Antibacterial Activity and Phenolic Content of Propolis Extracts Obtained by Different Extraction Methods. Nova Sci. 2018, 10, 397–412. [Google Scholar] [CrossRef]
- Bakchiche, B. Total Phenolic, Flavonoid Contents and Antioxidant Activities of Honey and Propolis Collected from the Region of Laghouat (South of Algeria). Int. J. Pharmacogn. Chin. Med. 2017, 1, 000110. [Google Scholar] [CrossRef]
- Andrews, J.M. Determination of Minimum Inhibitory Concentrations. J. Antimicrob. Chemother. 2001, 48, 5–16. [Google Scholar] [CrossRef]
- Petruzzi, L.; Rosaria Corbo, M.; Campaniello, D.; Speranza, B.; Sinigaglia, M.; Bevilacqua, A. Antifungal and Antibacterial Effect of Propolis: A Comparative Hit for Food-Borne Pseudomonas, Enterobacteriaceae and Fungi. Foods 2020, 9, 559. [Google Scholar] [CrossRef]
- Manzo-Sánchez, G.; Pérez-Ocón, R.; Chan-Cupul, W.; Silva-Jiménez, E.; Sánchez-Rangel, J.C.; Ayala-Zermeño, M.Á.; Galindo-Velasco, E. Actividad Antifúngica de Extractos Etanólicos de Propóleo Contra Mycosphaerella Fijiensis: Un Estudio in Vitro. Sci. Fungorum 2018, 47, 13–24. [Google Scholar] [CrossRef]
- Xu, L.; Zhang, B.; Qin, Y.; Li, F.; Yang, S.; Lu, P.; Wang, L.; Fan, J. Preparation and Characterization of Antifungal Coating Films Composed of Sodium Alginate and Cyclolipopeptides Produced by Bacillus Subtilis. Int. J. Biol. Macromol. 2020, 143, 602–609. [Google Scholar] [CrossRef]
- Dairi, N.; Ferfera-Harrar, H.; Ramos, M.; Garrigós, M.C. Cellulose Acetate/AgNPs-Organoclay and/or Thymol Nano-Biocomposite Films with Combined Antimicrobial/Antioxidant Properties for Active Food Packaging Use. Int. J. Biol. Macromol. 2019, 121, 508–523. [Google Scholar] [CrossRef]
- Kim, S.; Baek, S.-K.; Song, K. bin Physical and Antioxidant Properties of Alginate Films Prepared from Sargassum Fulvellum with Black Chokeberry Extract. Food Packag. Shelf Life 2018, 18, 157–163. [Google Scholar] [CrossRef]
- Yang, M.; Xia, Y.; Wang, Y.; Zhao, X.; Xue, Z.; Quan, F.; Geng, C.; Zhao, Z. Preparation and Property Investigation of Crosslinked Alginate/Silicon Dioxide Nanocomposite Films. J. Appl. Polym. Sci. 2016, 133, 43489. [Google Scholar] [CrossRef]
- Wai Chun, C.N.; Tajarudin, H.A.; Ismail, N.; Azahari, B.; Mohd Zaini Makhtar, M. Elucidation of Mechanical, Physical, Chemical and Thermal Properties of Microbial Composite Films by Integrating Sodium Alginate with Bacillus subtilis sp. Polymers 2021, 13, 2103. [Google Scholar] [CrossRef] [PubMed]
- Khodayari, M.; Basti, A.A.; Khanjari, A.; Misaghi, A.; Kamkar, A.; Shotorbani, P.M.; Hamedi, H. Effect of Poly(Lactic Acid) Films Incorporated with Different Concentrations of Tanacetum Balsamita Essential Oil, Propolis Ethanolic Extract and Cellulose Nanocrystals on Shelf Life Extension of Vacuum-Packed Cooked Sausages. Food Packag. Shelf Life 2019, 19, 200–209. [Google Scholar] [CrossRef]
- Sabo, B.; Bečica, T.; Keleš, N.; Kovačević, D.; Brozović, M. The Impact of Packaging Transparency on Product Attractiveness. J. Graph. Eng. Des. 2017, 8, 5–9. [Google Scholar] [CrossRef]
- Andreuccetti, C.; Carvalho, R.A.; Grosso, C.R.F. Effect of Hydrophobic Plasticizers on Functional Properties of Gelatin-Based Films. Food Res. Int. 2009, 42, 1113–1121. [Google Scholar] [CrossRef]
- Li, K.; Zhu, J.; Guan, G.; Wu, H. Preparation of Chitosan-Sodium Alginate Films through Layer-by-Layer Assembly and Ferulic Acid Crosslinking: Film Properties, Characterization, and Formation Mechanism. Int. J. Biol. Macromol. 2019, 122, 485–492. [Google Scholar] [CrossRef]
- Pastor, C.; Sánchez-González, L.; Cháfer, M.; Chiralt, A.; González-Martínez, C. Physical and Antifungal Properties of Hydroxypropylmethylcellulose Based Films Containing Propolis as Affected by Moisture Content. Carbohydr. Polym. 2010, 82, 1174–1183. [Google Scholar] [CrossRef]
- Cazón, P.; Vázquez, M.; Velazquez, G. Cellulose-Glycerol-Polyvinyl Alcohol Composite Films for Food Packaging: Evaluation of Water Adsorption, Mechanical Properties, Light-Barrier Properties and Transparency. Carbohydr. Polym. 2018, 195, 432–443. [Google Scholar] [CrossRef]
- Shahrampour, D.; Khomeiri, M.; Razavi, S.M.A.; Kashiri, M. Development and Characterization of Alginate/Pectin Edible Films Containing Lactobacillus Plantarum KMC 45. LWT 2020, 118, 108758. [Google Scholar] [CrossRef]
- Liu, Y.; Cai, Y.; Jiang, X.; Wu, J.; Le, X. Molecular Interactions, Characterization and Antimicrobial Activity of Curcumin–Chitosan Blend Films. Food Hydrocoll. 2016, 52, 564–572. [Google Scholar] [CrossRef]
- Bodini, R.B.; Sobral, P.J.A.; Favaro-Trindade, C.S.; Carvalho, R.A. Properties of Gelatin-Based Films with Added Ethanol–Propolis Extract. LWT Food Sci. Technol. 2013, 51, 104–110. [Google Scholar] [CrossRef]
- Carvalho, R.A.; Maria, T.M.C.; Moraes, I.C.F.; Bergo, P.V.A.; Kamimura, E.S.; Habitante, A.M.Q.B.; Sobral, P.J.A. Study of Some Physical Properties of Biodegradable Films Based on Blends of Gelatin and Poly(Vinyl Alcohol) Using a Response-Surface Methodology. Mater. Sci. Eng. C 2009, 29, 485–491. [Google Scholar] [CrossRef]
- Peres, R.S.; Zmozinski, A.V.; Brust, F.R.; Macedo, A.J.; Armelin, E.; Alemán, C.; Ferreira, C.A. Multifunctional Coatings Based on Silicone Matrix and Propolis Extract. Prog. Org. Coat. 2018, 123, 223–231. [Google Scholar] [CrossRef]
- Cortés-Higareda, M.; de Lorena Ramos-García, M.; Correa-Pacheco, Z.N.; Del Río-García, J.C.; Bautista-Baños, S. Nanostructured Chitosan/Propolis Formulations: Characterization and Effect on the Growth of Aspergillus Flavus and Production of Aflatoxins. Heliyon 2019, 5, e01776. [Google Scholar] [CrossRef]
- Franchin, M.; Cólon, D.F.; Castanheira, F.V.S.; da Cunha, M.G.; Bueno-Silva, B.; Alencar, S.M.; Cunha, T.M.; Rosalen, P.L. Vestitol Isolated from Brazilian Red Propolis Inhibits Neutrophils Migration in the Inflammatory Process: Elucidation of the Mechanism of Action. J. Nat. Prod. 2016, 79, 954–960. [Google Scholar] [CrossRef]
- Sforcin, J.M. Biological Properties and Therapeutic Applications of Propolis. Phytother. Res. 2016, 30, 894–905. [Google Scholar] [CrossRef]

| Treatment | a* | b* | L* | ∆E | Opacity |
|---|---|---|---|---|---|
| Control film | −2.13 ± 0.03 a | 6.30 ± 0.03 a | 84.94 ± 0.04 a | - | 2.66 a |
| 5% EEP film | 3.56 ± 0.02 b | 30.14 ± 0.03 b | 62. 27 ± 0.05 b | 69.27 ± 0.05 a | 4.43 b |
| 10% EEP film | 8 ± 0.2 c | 28.52 ± 0.04 c | 55.56 ± 0.03 c | 62.96 ± 0.03 b | 4.19 c |
| Samples | Thickness (mm) |
|---|---|
| Control film | 0.31 ± 0.043 a |
| 5% EEP film | 0.33 ± 0.061 a |
| 10% EEP film | 0.39 ± 0.038 b |
Disclaimer/Publisher’s Note: The statements, opinions and data contained in all publications are solely those of the individual author(s) and contributor(s) and not of MDPI and/or the editor(s). MDPI and/or the editor(s) disclaim responsibility for any injury to people or property resulting from any ideas, methods, instructions or products referred to in the content. |
© 2023 by the authors. Licensee MDPI, Basel, Switzerland. This article is an open access article distributed under the terms and conditions of the Creative Commons Attribution (CC BY) license (https://creativecommons.org/licenses/by/4.0/).
Share and Cite
Abarca, R.L.; Vargas, F.; Medina, J.; Paredes, J.C.; López, B.C.; Ortiz, P.A.; Vargas-Bello-Pérez, E. Development and Characterization of Films with Propolis to Inhibit Mold Contamination in the Dairy Industry. Foods 2023, 12, 1633. https://doi.org/10.3390/foods12081633
Abarca RL, Vargas F, Medina J, Paredes JC, López BC, Ortiz PA, Vargas-Bello-Pérez E. Development and Characterization of Films with Propolis to Inhibit Mold Contamination in the Dairy Industry. Foods. 2023; 12(8):1633. https://doi.org/10.3390/foods12081633
Chicago/Turabian StyleAbarca, Romina L., Francisco Vargas, Javiera Medina, Juan Carlos Paredes, Bernardo Carrillo López, Pablo A. Ortiz, and Einar Vargas-Bello-Pérez. 2023. "Development and Characterization of Films with Propolis to Inhibit Mold Contamination in the Dairy Industry" Foods 12, no. 8: 1633. https://doi.org/10.3390/foods12081633
APA StyleAbarca, R. L., Vargas, F., Medina, J., Paredes, J. C., López, B. C., Ortiz, P. A., & Vargas-Bello-Pérez, E. (2023). Development and Characterization of Films with Propolis to Inhibit Mold Contamination in the Dairy Industry. Foods, 12(8), 1633. https://doi.org/10.3390/foods12081633

